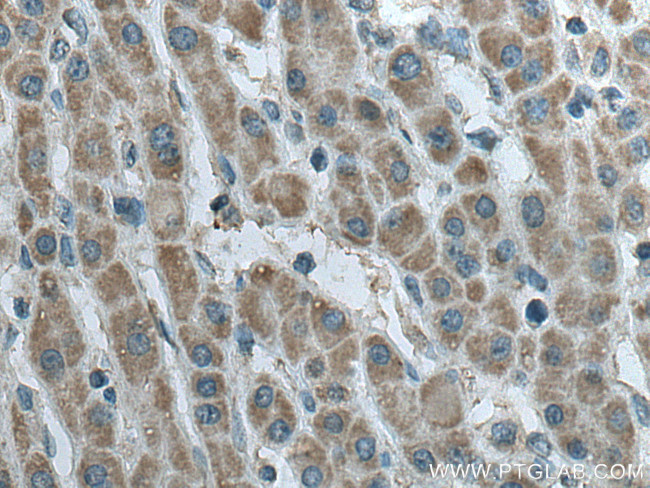
SDHB Antibody in Immunohistochemistry (Paraffin) (IHC (P))

Search
Proteintech
SDHB Monoclonal Antibody (1A2A5)
{{$productOrderCtrl.translations['antibody.pdp.commerceCard.promotion.promotions']}}
{{$productOrderCtrl.translations['antibody.pdp.commerceCard.promotion.viewpromo']}}
{{$productOrderCtrl.translations['antibody.pdp.commerceCard.promotion.promocode']}}: {{promo.promoCode}} {{promo.promoTitle}} {{promo.promoDescription}}. {{$productOrderCtrl.translations['antibody.pdp.commerceCard.promotion.learnmore']}}
产品信息
67600-1-IG
种属反应
宿主/亚型
分类
类型
克隆号
抗原
偶联物
形式
浓度
规格
纯化类型
保存液
内含物
保存条件
运输条件
产品详细信息
Aliquoting is unnecessary for -20°C storage.
靶标信息
Complex II of the respiratory chain, which is specifically involved in the oxidation of succinate, carries electrons from FADH to CoQ. The complex is composed of four nuclear-encoded subunits and is localized in the mitochondrial inner membrane. The iron-sulfur subunit is highly conserved and contains three cysteine-rich clusters which may comprise the iron-sulfur centers of the enzyme. Sporadic and familial mutations in this gene result in paragangliomas and pheochromocytoma, and support a link between mitochondrial dysfunction and tumorigenesis.
仅用于科研。不用于诊断过程。未经明确授权不得转售。
生物信息学
蛋白别名: FLJ92337; Ip; iron-sulfur subunit; Iron-sulfur subunit of complex II; Malate dehydrogenase [quinone] iron-sulfur subunit; OTTHUMP00000044624; Succinate dehydrogenase [ubiquinone] iron-sulfur subunit, mitochondrial; succinate dehydrogenase complex subunit B; succinate dehydrogenase complex, subunit B, iron sulfur (Ip); succinate-ubiquinone oxidoreductase Ip subunit precursor; unnamed protein product
基因别名: 0710008N11Rik; CWS2; IP; MC2DN4; PGL4; PPGL4; SDH; SDH1; SDH2; SDHB; SDHIP
UniProt ID: (Human) P21912, (Mouse) Q9CQA3, (Rat) P21913
Entrez Gene ID: (Human) 6390, (Mouse) 67680, (Rat) 298596